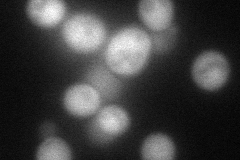

View description
Protein involved in homologous recombination in mitochondria and in transcription regulation in nucleus; binds to activation domains of acidic activators; required for recombination-dependent mtDNA partitioning
Localization:
Intensity:
Fold change:
Significance:
-
C’ GFP library in SD

mitochondria77.47 -
N' NOP1pr-GFP in SD

cytosol75.9238 -
N' TEF2pr-mCherry in SD
cytosol68.4038 -
N' NATIVEpr-GFP in SD

below threshold16.508 -
N' TEF2pr-VC and Cyto-VN in SD

#N/A0 -
C’ GFP library in SD+DTT

mitochondria90.111.16No -
C’ GFP library in SD+H2O2

mitochondria63.160.81No -
C’ GFP library in Starvation Media

mitochondria102.81.32No -
C’ GFP library on the background of Pup2-DaMP

mitochondria -
C’ GFP library on the background of CCT mutant

mitochondria69.96480.903058No
